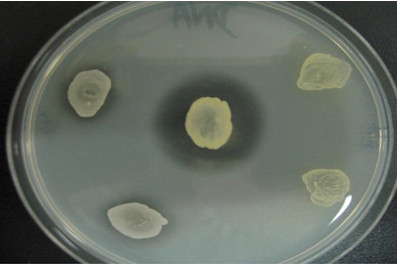

如何提高病原菌检出率?
社区获得性肺炎(CAP)属于临床常见病,具有较高的发病率和死亡率。虽然CAP的诊断不难,但在多数实验室,引起下呼吸道感染的三大病原菌:肺炎链球菌、流感嗜血杆菌,卡他莫拉菌的分离率几乎为零。所以采取必要的措施,分离出这三种病原菌,是提高病原菌检出率的最有效方法。
3种最常见的社区获得性下呼吸道病原菌最有效的抗生素是:
肺炎链球菌,青霉素95%敏感;嗜血杆菌:阿莫西林/克拉维酸100%;卡他菌:阿莫西林/克拉维酸95%。可见快速鉴定上述3种菌,是对合理使用抗生素做的最实际的工作。

图1:痰涂片镜检,肺炎链球菌呈“矛头状”或“瓜子仁”状,与WBC伴行(箭头所示)
图2:肺链在二氧化碳环境生长的菌落形态
痰涂片染色镜检,见到有荚膜的阳性双球菌,瓜子仁样相对排列,不被WBC吞噬可确定为肺炎链球菌。此种标本在培养基营养成分不是很好,而又无二氧化碳箱的实验室,即使生长的菌落无肺炎链球菌的t特征,也要做奥普托欣敏感试验,并在生长了疑似肺链的平板上直接做胆汁溶菌试验。
卡他莫拉菌的菌落形态在显微镜下与非致病原奈瑟菌相同,但痰涂片镜检完全不同,卡他菌与白细胞伴行或被吞噬,非致病菌不致病,不会出现白细胞,只与上皮细胞伴行。
接种的血平板与巧克力平板放二氧化碳温箱,培养24小时,细菌生长良好;中国蓝或麦康凯平板生长不良或不生长。

图3:痰标本直接涂片,WBC吞噬卡他莫拉菌
图4:卡他菌菌落(灰白、干燥,易碎)
血、巧克力、中国蓝三种平板卡他生长

鉴定步骤如下:
1.菌落涂片,革兰氏阴性双球菌;2.氧化酶试验:阳性;3 .将待测菌落点种在DNA酶平板,同时接种金葡菌,做阳性对照。35度培养24小时,滴加1N盐酸溶液盖满平板,在菌落周围出现透明环为阳性;4.痰涂片镜检见到白细胞吞噬或伴行阴性双球菌的现象与上述三个试验有高度的一致性。
平板中心是金葡菌,DNA酶阳性。左侧两个菌落是卡他莫拉菌,右侧是非致病奈瑟菌。原理:细菌产生DNA酶使长链水解,水解后的寡核苷酸链可溶于酸,菌落周围形成透明环。

DNA酶琼脂中加入甲基绿,可与培养基中的长链DNA结合成稳定的绿色复合物,当DNA被水解时,甲基绿释放,菌落变为无色。此平板因太厚,产DNA酶的卡他菌没有能力水解琼脂深层的DNA,绿色依然存在,使结果判断为阴性。

在上述平板上加入1N盐酸后,被卡他菌水解的DNA长链成为寡核苷酸短链溶解在盐酸中,菌落周围出现透明环。此方法为比甲基绿方法敏感。
分离流感嗜血杆菌的关键是优质的巧克力平板和二氧化碳温箱,此菌只在放入二氧化碳温箱的巧克力平板上生长,灰白,湿润,1毫米大小,半透明。

图5:痰标本直接涂片,WBC伴行嗜血杆菌
图6:流感嗜血杆菌菌落(扁平,灰白,光滑、湿润)
鉴定步骤:
1:革兰氏阴性小杆菌;2:只生长在放入二氧化碳的巧克力平板;3:因子生长2及卫星现象。
卫星现象是血平板和MH平板上分别涂待测的嗜血杆菌,用金黄色葡萄球菌划在两种平板上。只有在血平板上金黄色葡萄球菌有细菌生长,MH平板上不生长,才能确定为流感嗜血杆菌。
所用的金黄色葡萄球菌必须在MH平板上挑取,生长在血平板上的金黄色葡萄球菌,因沾上少量的V因子在MH平板上,使金黄色葡萄球菌周围出现细菌,而将待测的流感嗜血杆菌误认为副流感。
最好使用因子生长试验方法,用胰蛋白胨大豆琼脂配制平板,将待测的嗜血杆菌涂在平板上贴V、X、及V+X因子纸片放二氧化碳温箱培养24小时,只在V+X因子周围生长的是流感嗜血杆菌,V+X因子及V因子周围都生长的是副流感嗜血杆菌。

